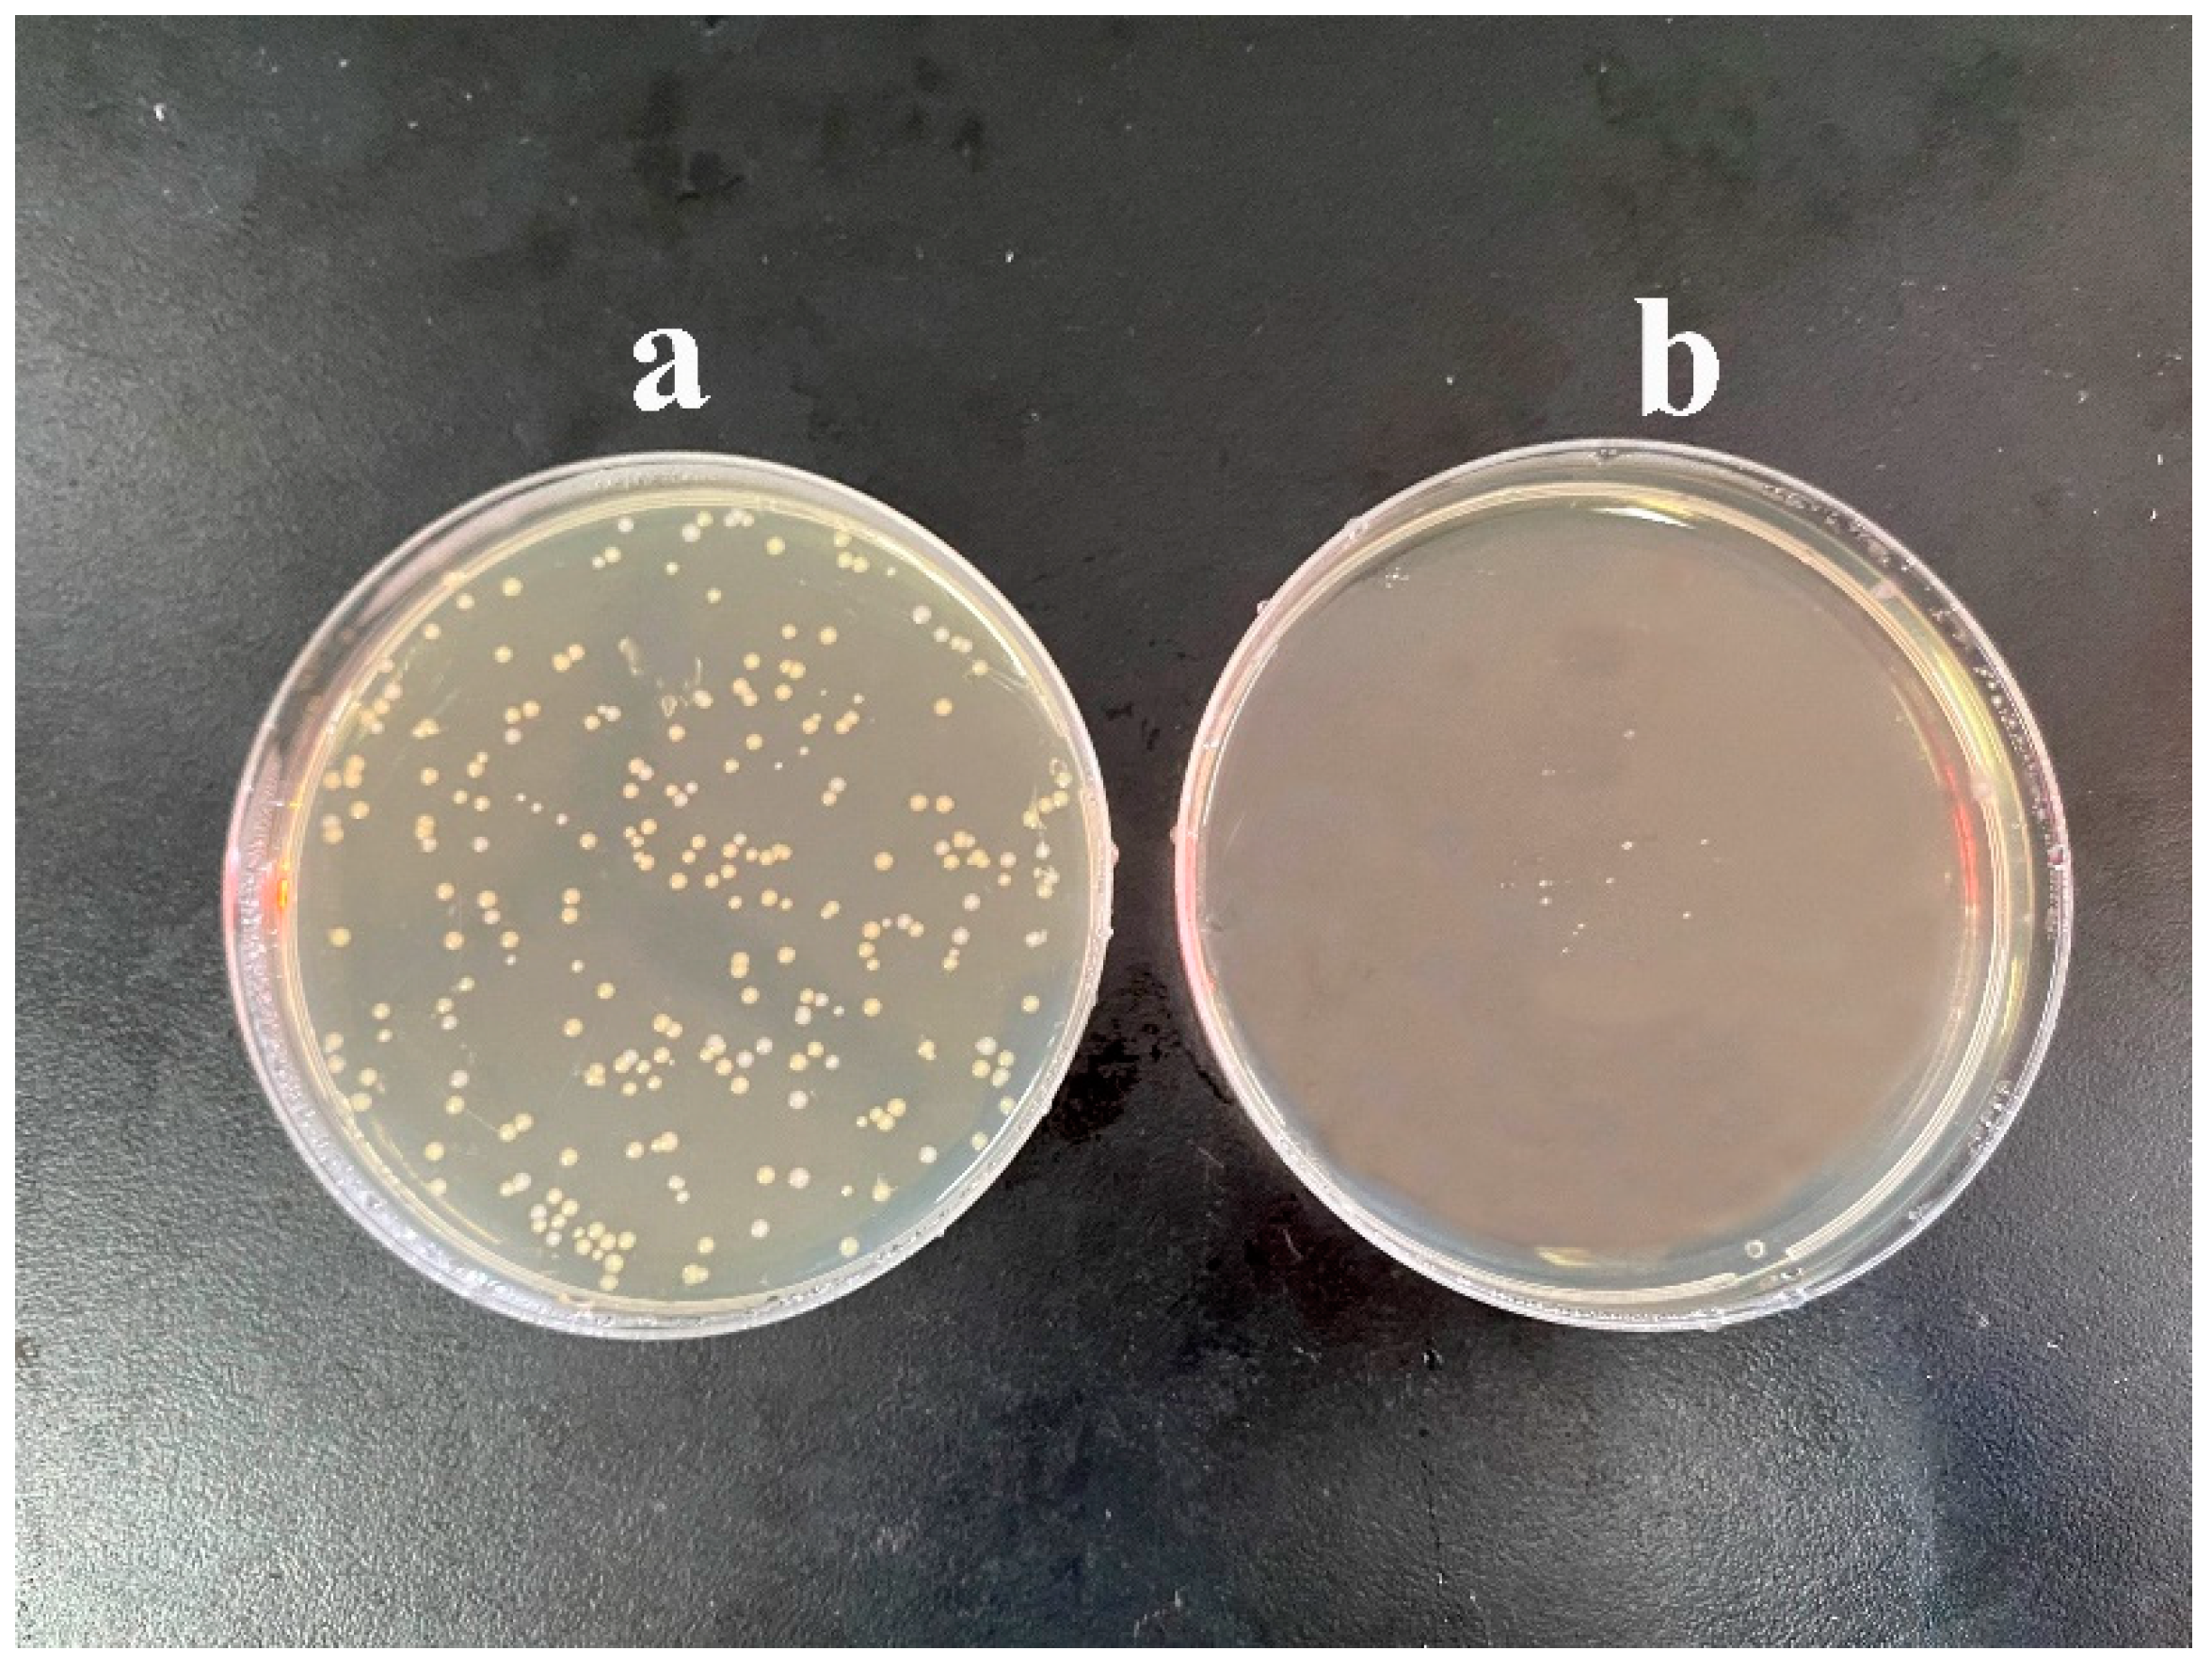

Preparation of Silica Aerogel/Resin Composites and Their Application in Dental Restorative Materials
Abstract
:1. Introduction
2. Results
2.1. Microstructure Analysis of Silica Aerogel/Resin Composites
2.2. Analysis of the Chemical Structure of the Silica Aerogel/Resin Composites
2.3. Analysis of the Thermal Stability Properties of Silica Aerogel/Resin Composites
2.4. Effect of Silica Aerogel on the Mechanical Properties of Silica Aerogel/Resin Composites
2.5. Analysis of the Water Sorption and Solubility of the Silica Aerogel/Resin Composites
2.6. Analysis of Shore Hardness of Silica Aerogel/Resin Composites
2.7. Analysis of Antibacterial Properties of Silica Aerogel/Resin Composites
3. Conclusions
4. Materials and Methods
4.1. Materials
4.2. Preparation of Silica Aerogel/Resin Composites
4.3. Bacteriostasis Experiment
4.3.1. Preparation of the Culture Medium
4.3.2. Preparation of Bacterial Suspension
4.3.3. Antibacterial Test
4.4. Characterization
Supplementary Materials
Author Contributions
Funding
Institutional Review Board Statement
Informed Consent Statement
Data Availability Statement
Acknowledgments
Conflicts of Interest
References
- Lee, H.; Lomazzi, M.; Lee, A.; Bedi, R. Global oral health in the framework of the Global Charter for the Public’s Health. J. Public Health Policy 2018, 39, 245–253. [Google Scholar] [CrossRef] [PubMed]
- Featherstone, J.D.B. The continuum of dental caries—Evidence for a dynamic disease process. J. Dent. Res. 2004, 83, 39–42. [Google Scholar] [CrossRef] [PubMed]
- Totiam, P.; González-Cabezas, C.; Fontana, M.R.; Zero, D.T. A new in vitro model to study the relationship of gap size and secondary caries. Caries Res. 2007, 41, 467–473. [Google Scholar] [CrossRef] [PubMed]
- Zhang, X.; Zhang, Q.; Meng, X.; Ye, Y.; Feng, D.; Xue, J.; Wang, H.; Huang, H.; Wang, M.; Wang, J. Rheological and Mechanical Properties of Resin-Based Materials Applied in Dental Restorations. Polymers 2021, 13, 2975. [Google Scholar] [CrossRef]
- Moncada, G.; Fernandez, E.; Mena, K.; Martin, J.; Vildosola, P.; De Oliveira Junior, O.B.; Estay, J.; Mjor, I.A.; Gordan, V.V. Seal, replacement or monitoring amalgam restorations with occlusal marginal defects? Results of a 10-year clinical trial. J. Dent. 2015, 43, 1371–1378. [Google Scholar] [CrossRef] [PubMed]
- Correa, M.B.; Peres, M.A.; Peres, K.G.; Horta, B.L.; Barros, A.D.; Demarco, F.F. Amalgam or composite resin? Factors influencing the choice of restorative material. J. Dent. 2012, 40, 703–710. [Google Scholar] [CrossRef]
- Umesi, D.C.; Oremosu, O.A.; Makanjuola, J.O. Amalgam phase down: Baseline data preceding implementation in Nigeria. Int. Dent. J. 2020, 70, 161–166. [Google Scholar] [CrossRef] [PubMed]
- Chen, M.H. Update on dental nanocomposites. J. Dent. Res. 2010, 89, 549–560. [Google Scholar] [CrossRef] [PubMed]
- Zhang, Y.; Huang, C.; Chang, J. Ca-Doped mesoporous SiO2/dental resin composites with enhanced mechanical properties, bioactivity and antibacterial properties. J. Mater. Chem. 2018, 6, 477–486. [Google Scholar] [CrossRef] [PubMed]
- Cho, K.; Yasir, M.; Jung, M.; Willcox, M.D.P.; Stenzel, M.H.; Rajan, G.; Farrar, P.; Prusty, B.G. Hybrid engineered dental composites by multiscale reinforcements with chitosan-integrated halloysite nanotubes and S-glass fibers. Compos. Eng. 2020, 202, 108448–108457. [Google Scholar] [CrossRef]
- Gong, H.; Guo, X.; Cao, D.; Gao, P.; Feng, D.; Zhang, X.; Shi, Z.; Zhang, Y.; Zhu, S.; Cui, Z. Photopolymerizable and moisture-curable polyurethanes for dental adhesive applications to increase restoration durability. J. Mater. Chem. 2019, 7, 744–754. [Google Scholar] [CrossRef] [PubMed]
- Zhou, X.; Huang, X.; Li, M.; Peng, X.; Wang, S.; Zhou, X.; Cheng, L. Development and status of resin composite as dental restorative materials. J. Appl. Polym. Sci. 2019, 136, 48180–48191. [Google Scholar] [CrossRef] [Green Version]
- Fugolin, A.P.P.; Pfeifer, C.S. New Resins for Dental Composites. J. Dent. Res. 2017, 96, 1085–1091. [Google Scholar] [CrossRef] [PubMed]
- Xu, X.; He, L.; Zhu, B.; Li, J.; Li, J. Advances in polymeric materials for dental applications. Polym. Chem. 2016, 8, 807–823. [Google Scholar] [CrossRef]
- Mirica, I.C.; Furtos, G.; Baldea, B.; Lucaciu, O.; Ilea, A.; Moldovan, M.; Campian, R.S. Influence of Filler Loading on the Mechanical Properties of Flowable Resin Composites. Materials 2020, 13, 1477. [Google Scholar] [CrossRef] [PubMed] [Green Version]
- Behl, S.; Raju; Rajan, G.; Ellakwa, A.; Farrar, P.; Prusty, B.G. Physical and mechanical characterisation of flowable dental composites reinforced with short aspect ratio micro-sized S-Glass fibres. Mater. Sci. Eng. Mater. Biol. Appl. 2020, 111, 110771–110780. [Google Scholar] [CrossRef] [PubMed]
- Pieniak, D.; Walczak, A.; Walczak, M.; Przystupa, K.; Niewczas, A.M. Hardness and Wear Resistance of Dental Biomedical Nanomaterials in a Humid Environment with Non-Stationary Temperatures. Materials 2020, 13, 1255. [Google Scholar] [CrossRef] [Green Version]
- Pratap, B.; Ravi Kant, G.; Denis, L.; Goswami, D. Evaluation of polymerization shrinkage and Vickers hardness for restorative dental composites. Mater. Today Proc. 2020, 21, 1563–1565. [Google Scholar] [CrossRef]
- Kolb, C.; Gumpert, K.; Wolter, H.; Sextl, G. Highly translucent dental resin composites through refractive index adaption using zirconium dioxide nanoparticles and organic functionalization. Dent. Mater. 2020, 36, 1332–1342. [Google Scholar] [CrossRef]
- Fu, W.; Wang, L.; He, J. Evaluation of mechanical properties and shrinkage stress of thiol-ene-methacrylate dental composites with synthesized fluorinated allyl ether. J. Mech. Behav. Biomed. Mater. 2019, 95, 53–59. [Google Scholar] [CrossRef]
- Yang, D.L.; Cui, Y.N.; Sun, Q.; Liu, M.; Niu, H.; Wang, J.X. Antibacterial activity and reinforcing effect of SiO2-ZnO complex cluster fillers for dental resin composites. Biomater. Sci. 2021, 9, 1795–1804. [Google Scholar] [CrossRef] [PubMed]
- Boaro, L.C.C.; Campos, L.M.; Varca, G.H.C.; Dos Santos, T.M.R.; Marques, P.A.; Sugii, M.M.; Saldanha, N.R.; Cogo-Muller, K.; Brandt, W.C.; Braga, R.R.; et al. Antibacterial resin-based composite containing chlorhexidine for dental applications. Dent. Mater. 2019, 35, 909–918. [Google Scholar] [CrossRef] [PubMed]
- Yan, Y.; Chen, C.; Chen, B.; Shen, J.; Zhang, H.; Xie, H. Effects of hydrothermal aging, thermal cycling, and water storage on the mechanical properties of a machinable resin-based composite containing nano-zirconia fillers. J. Mech. Behav. Biomed. Mater. 2020, 102, 103522–103529. [Google Scholar] [CrossRef]
- Abaszadeh, M.; Mohammadi, M.; Mohammadzadeh, I. Biocompatibility of a New Antibacterial Compound and its Effect on the Mechanical Properties of Flowable Dental Composites (Animal Study). J. Dent. 2020, 21, 56–62. [Google Scholar] [CrossRef]
- Yaghmoor, R.B.; Xia, W.; Ashley, P.; Allan, E.; Young, A.M. Effect of Novel Antibacterial Composites on Bacterial Biofilms. J. Funct. Biomater. 2020, 11, 55. [Google Scholar] [CrossRef]
- Yang, D.-L.; Sun, Q.; Niu, H.; Wang, R.-L.; Wang, D.; Wang, J.-X. The properties of dental resin composites reinforced with silica colloidal nanoparticle clusters: Effects of heat treatment and filler composition. Compos. Eng. 2020, 186, 107791–107799. [Google Scholar] [CrossRef]
- Wang, Y.; Zhu, M.; Zhu, X.X. Functional fillers for dental resin composites. Acta Biomater. 2021, 122, 50–65. [Google Scholar] [CrossRef]
- Wang, R.; Habib, E.; Zhu, X.X. Evaluation of the filler packing structures in dental resin composites: From theory to practice. Dent. Mater. 2018, 34, 1014–1023. [Google Scholar] [CrossRef]
- Alrahlah, A.; Khan, R.; Al-Odayni, A.B.; Saeed, W.S.; Bautista, L.S.; Vohra, F. Evaluation of Synergic Potential of rGO/SiO2 as Hybrid Filler for BisGMA/TEGDMA Dental Composites. Polymers 2020, 12, 3025. [Google Scholar] [CrossRef]
- Yadav, R.; Meena, A. Effect of aluminium oxide, titanium oxide, hydroxyapatite filled dental restorative composite materials on physico-mechanical properties. Ceram. Int. 2022, 48, 20306–20314. [Google Scholar] [CrossRef]
- Bukovinszky, K.; Szaloki, M.; Csarnovics, I.; Bonyar, A.; Petrik, P.; Kalas, B.; Daroczi, L.; Keki, S.; Kokenyesi, S.; Hegedus, C. Optimization of Plasmonic Gold Nanoparticle Concentration in Green LED Light Active Dental Photopolymer. Polymers 2021, 13, 275. [Google Scholar] [CrossRef] [PubMed]
- Chen, H.; Wang, R.; Qian, L.; Liu, H.; Wang, J.; Zhu, M. Surface modification of urchin-like serried hydroxyapatite with sol-gel method and its application in dental composites. Compos. Eng. 2020, 182, 107621–107627. [Google Scholar] [CrossRef]
- Yang, J.; Shen, J.; Wu, X.; He, F.; Xie, H.; Chen, C. Effects of nano-zirconia fillers conditioned with phosphate ester monomers on the conversion and mechanical properties of Bis-GMA- and UDMA-based resin composites. J. Dent. 2020, 94, 103306–103315. [Google Scholar] [CrossRef] [PubMed]
- Barot, T.; Rawtani, D.; Kulkarni, P. Physicochemical and biological assessment of silver nanoparticles immobilized Halloysite nanotubes-based resin composite for dental applications. Heliyon 2020, 6, e03601–e03610. [Google Scholar] [CrossRef] [PubMed]
- Guimaraes, G.M.F.; Bronze-Uhle, E.S.; Lisboa-Filho, P.N.; Fugolin, A.P.P.; Borges, A.F.S.; Gonzaga, C.C.; Pfeifer, C.S.; Furuse, A.Y. Effect of the addition of functionalized TiO2 nanotubes and nanoparticles on properties of experimental resin composites. Dent. Mater. 2020, 36, 1544–1556. [Google Scholar] [CrossRef] [PubMed]
- Ástvaldsdóttir, Á.; Dagerhamn, J.; van Dijken, J.W.; Naimi-Akbar, A.; Sandborgh-Englund, G.; Tranæus, S.; Nilsson, M. Longevity of posterior resin composite restorations in adults—A systematic review. J. Dent. 2015, 43, 934–954. [Google Scholar] [CrossRef] [PubMed]
- Demarco, F.F.; Collares, K.; Coelho-de-Souza, F.H.; Correa, M.B.; Cenci, M.S.; Moraes, R.R.; Opdam, N.J. Anterior composite restorations: A systematic review on long-term survival and reasons for failure. Dent. Mater. 2015, 31, 1214–1224. [Google Scholar] [CrossRef] [PubMed]
- Collares, K.; Opdam, N.J.M.; Laske, M.; Bronkhorst, E.M.; Demarco, F.F.; Correa, M.B.; Huysmans, M. Longevity of Anterior Composite Restorations in a General Dental Practice-Based Network. J. Dent. Res. 2017, 96, 1092–1099. [Google Scholar] [CrossRef]
- Wang, R.; Habib, E.; Zhu, X.X. Synthesis of wrinkled mesoporous silica and its reinforcing effect for dental resin composites. Dent. Mater. 2017, 33, 1139–1148. [Google Scholar] [CrossRef]
- Aminoroaya, A.; Bagheri, R.; Nouri Khorasani, S.; Talebi, Z.; Derakhshanfar, P.; Esmaeely Neisiany, R. Mesoporous silica aerogel reinforced dental composite: Effects of microstructure and surface modification. J. Mech. Behav. Biomed. Mater. 2022, 125, 104947–104955. [Google Scholar] [CrossRef]
- Zhang, Y.; Xiang, L.; Shen, Q.; Li, X.; Wu, T.; Zhang, J.; Nie, C. Rapid synthesis of dual-mesoporous silica aerogel with excellent adsorption capacity and ultra-low thermal conductivity. J. Non-Cryst. Solids 2021, 555, 120547–120555. [Google Scholar] [CrossRef]
- Al-Oweini, R.; El-Rassy, H. Synthesis and characterization by FTIR spectroscopy of silica aerogels prepared using several Si(OR)4 and R″Si(OR′)3 precursors. J. Mol. Struct. 2009, 919, 140–145. [Google Scholar] [CrossRef]
- Samuel, S.P.; Li, S.; Mukherjee, I.; Guo, Y.; Patel, A.C.; Baran, G.; Wei, Y. Mechanical properties of experimental dental composites containing a combination of mesoporous and nonporous spherical silica as fillers. Dent. Mater. 2009, 25, 296–301. [Google Scholar] [CrossRef] [PubMed]
- Luo, S.; Zhu, W.; Liu, F.; He, J. Preparation of a Bis-GMA-Free Dental Resin System with Synthesized Fluorinated Dimethacrylate Monomers. Int. J. Mol. Sci. 2016, 17, 2014. [Google Scholar] [CrossRef] [PubMed] [Green Version]
- Costella, A.M.; Trochmann, J.L.; Oliveira, W.S. Water sorption and diffusion coefficient through an experimental dental resin. J. Mater. Sci. Mater. Med. 2010, 21, 67–72. [Google Scholar] [CrossRef] [PubMed]
- Godoy-Gallardo, M.; Eckhard, U.; Delgado, L.M.; de Roo Puente, Y.J.D.; Hoyos-Nogues, M.; Gil, F.J.; Perez, R.A. Antibacterial approaches in tissue engineering using metal ions and nanoparticles: From mechanisms to applications. Bioact. Mater. 2021, 6, 4470–4490. [Google Scholar] [CrossRef] [PubMed]
- Peng, C.; Zhong, J.; Ma, X.; Huang, A.; Chen, G.; Luo, W.; Zeng, B.; Yuan, C.; Xu, Y.; Dai, L. Transparent, hard-wearing and bio-based organic/silica hybrid coating for bamboo with enhanced flame retardant and antifungal properties. Prog. Org. Coat. 2022, 167, 106830. [Google Scholar] [CrossRef]

| Sample | Silica Aerogel Content (%) | WS (%) |
|---|---|---|
| SA/R-0 | 0 | 1.85 ± 0.21 |
| SA/R-7 | 5 | 0.48 ± 0.05 |
| SA/R-8 | 7.5 | 0.44 ± 0.06 |
| SA/R-9 | 10 | 0.37 ± 0.05 |
| SA/R-2 | 12.5 | 0.30 ± 0.06 |
| SA/R-10 | 15 | 0.26 ± 0.04 |
| Sample | Silica Aerogel Content (%) | Shore Hardness (A) |
|---|---|---|
| SA/R-0 | 0 | 70 |
| SA/R-7 | 5 | 85 |
| SA/R-8 | 7.5 | 95 |
| SA/R-9 | 10 | 87 |
| SA/R-2 | 12.5 | 100 |
| SA/R-10 | 15 | 88 |
| Sample | Bis-GMA:TEGDMA | Particle Sizes (μm) | SA (wt%) |
|---|---|---|---|
| SA/R-0 | 1:1 | - | 0 |
| SA/R-1 | 1:2 | 50 | 12.5 |
| SA/R-2 | 1:1 | 50 | 12.5 |
| SA/R-3 | 3:2 | 50 | 12.5 |
| SA/R-4 | 2:1 | 50 | 12.5 |
| SA/R-5 | 1:1 | 15 | 12.5 |
| SA/R-6 | 1:1 | 30 | 12.5 |
| SA/R-7 | 1:1 | 50 | 5 |
| SA/R-8 | 1:1 | 50 | 7.5 |
| SA/R-9 | 1:1 | 50 | 10 |
| SA/R-10 | 1:1 | 50 | 15 |
| SA/R-A | 1:2 | - | 0 |
| SA/R-B | 3:2 | - | 0 |
| SA/R-C | 2:1 | - | 0 |
Publisher’s Note: MDPI stays neutral with regard to jurisdictional claims in published maps and institutional affiliations. |
© 2022 by the authors. Licensee MDPI, Basel, Switzerland. This article is an open access article distributed under the terms and conditions of the Creative Commons Attribution (CC BY) license (https://creativecommons.org/licenses/by/4.0/).
Share and Cite
Cheng, J.; Deng, Y.; Tan, Y.; Li, J.; Fei, Y.; Wang, C.; Zhang, J.; Niu, C.; Fu, Q.; Lu, L. Preparation of Silica Aerogel/Resin Composites and Their Application in Dental Restorative Materials. Molecules 2022, 27, 4414. https://doi.org/10.3390/molecules27144414
Cheng J, Deng Y, Tan Y, Li J, Fei Y, Wang C, Zhang J, Niu C, Fu Q, Lu L. Preparation of Silica Aerogel/Resin Composites and Their Application in Dental Restorative Materials. Molecules. 2022; 27(14):4414. https://doi.org/10.3390/molecules27144414
Chicago/Turabian StyleCheng, Jingru, Yuyi Deng, Yujin Tan, Jiawei Li, Yongsheng Fei, Congcong Wang, Jingjing Zhang, Chenxi Niu, Qian Fu, and Lingbin Lu. 2022. "Preparation of Silica Aerogel/Resin Composites and Their Application in Dental Restorative Materials" Molecules 27, no. 14: 4414. https://doi.org/10.3390/molecules27144414
APA StyleCheng, J., Deng, Y., Tan, Y., Li, J., Fei, Y., Wang, C., Zhang, J., Niu, C., Fu, Q., & Lu, L. (2022). Preparation of Silica Aerogel/Resin Composites and Their Application in Dental Restorative Materials. Molecules, 27(14), 4414. https://doi.org/10.3390/molecules27144414
